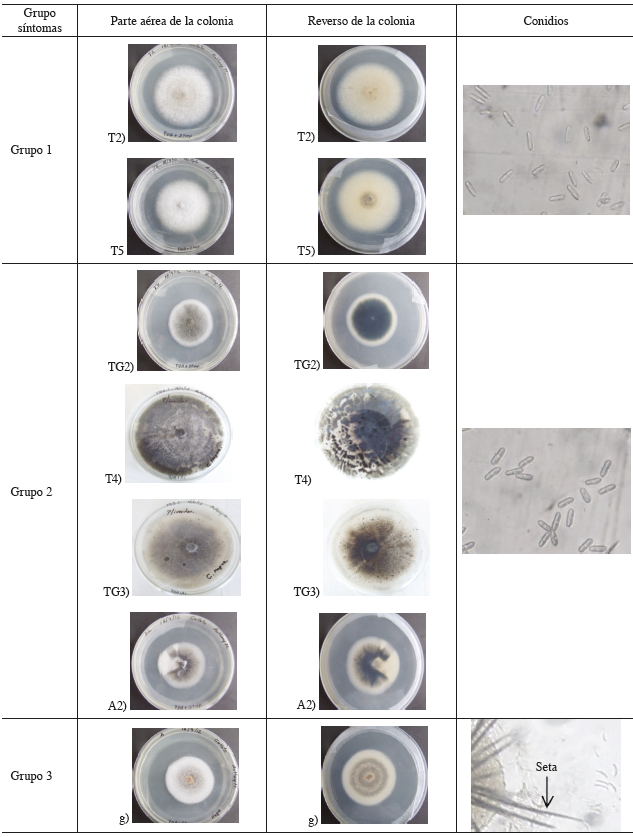
Morfolog&iacute;a de los aislamientos de Colletotrichum spp., recuperados de diferentes s&iacute;ntomas de antracnosis en frutos de papaya, h&iacute;brido Pococ&iacute;, recolectados en Gu&aacute;cimo, Lim&oacute;n, Costa Rica. 2012.

Artículo
Identificación de especies del géneroColletotrichumasociadas a la antracnosis en papaya (Carica papayaL.) En Costa Rica1
Identification of Colletotrichum species associated with anthracnose in papaya (Carica papaya L.) in Costa Rica.
Identificación de especies del géneroColletotrichumasociadas a la antracnosis en papaya (Carica papayaL.) En Costa Rica1
Agronomía Costarricense, vol. 41, núm. 1, pp. 69-80, 2017
Universidad de Costa Rica. Colegio de Ingenieros y Agrónomos. Ministerio de Agricultura y Ganadería
Recepción: 29 Noviembre 2016
Aprobación: 20 Enero 2017
Resumen: La antracnosis, causada por Colletotrichum spp., es una de la enfermedades poscosecha más importantes en papaya. En este estudio, frutas de papaya, híbrido Pococí, recolectados en plantaciones ubicadas en el cantón de Guácimo, provincia de Limón, presentaron 7 síntomas de antracnosis, luego de un período de almacenamiento. De cada síntoma se obtuvieron aislados de Colletotrichum en medio de cultivo PDA (papa-dextrosa-agar). Los aislamientos se clasificaron en 3 grupos según la similitud de los síntomas y la morfología de la colonia. El análisis de la secuencia de la región espaciadora interna transcrita (ITS) del ADN ribosomal reveló que los aislamientos pertenecieron a 3 especies del género Colletotrichum: C. gloeosporioides sensu lato, C. magnum y C. capsici (C. truncatum). La identificación de las especies fue confirmada con imprimadores taxón específico para C. gloeosporioides e imprimadores especie-específicos para C. magnum. Las 3 especies identificadas mostraron ser patogénicas sobre frutas de papaya. Las especies C. magnum y C. capsici (C. truncatum) se registran por primera vez en Costa Rica, como agentes causales de la antracnosis en papaya.
Palabras clave: Poscosecha, C. magna, complejo C. Gloeosporioides, patogenicidad, caracterización molecular.
Abstract: Anthracnose, caused by Colletotrichum spp., is one of the most important postharvest diseases in papaya. In this study, papaya fruits, Pococí hybrid, collected from orchards located in Guácimo, Limón province, showed 7 distinct anthracnose symptoms after a storage period. Colletotrichum isolates were obtained from each symptom on PDA (potato-desxtrosa-agar) medium. Isolates were classified in 3 groups based on symptoms similarities and colony morphology. Sequence analysis of the internal transcribed spacer (ITS) region revealed that isolates belonged to three Colletotrichum species: C. gloeosporioides sensu lato, C. magnum and C. capsici (C. truncatum). Species identification was confirmed using taxonspecific primer for C. gloeosporioides sensu lato and species-specific primer for C. magnum. Pathogenicity tests on papaya fruits showed that all species could induce anthracnose. C. magnum and C. capsici species are registered for the first time in Costa Rica as causal anthracnose pathogens in papaya.
Keywords: Postharvest, C. magna, C. gloeosporioides species complex, pathogenicity, molecular characterization..
Introducción
En Costa Rica, el cultivo de papaya se reactivó en los últimos años, principalmente por la adopción del híbrido “Pococí”, con buena aceptación tanto en el mercado nacional como el internacional. Sin embargo, una limitante en la comercialización de la fruta de papaya es su alta susceptibilidad a enfermedades fungosas en poscosecha, principalmente a la antracnosis (Bailey y Jeger 1992).
Los síntomas iniciales de la antracnosis en frutos de papaya consisten en lesiones circulares, hundidas, blandas, limitadas por un halo café claro y traslúcido, que se desarrollan en la epidermis de la fruta y aumentan de tamaño hasta observarse lesiones húmedas y colonias de esporas de color naranja o rosado en la parte central de la lesión (Álvarez y Nishijima 1978 citados por Citlali et al. 2005). Se ha observado una alta variabilidad en los síntomas de antracnosis en frutas de papaya atribuida tanto a la infección por diferentes especies de Colletotrichum como a la reacción de las diferentes variedades, o sea a la diversidad genética del hospedante (Simmonds 1965, Durán y Mora 1987).
Colletotrichum gloeosporioides y C. acutatum han sido tradicionalmente identificadas como las especies causantes de la antracnosis en papaya (Durán y Mora 1987, Rampersad
2011, Barquero et al. 2013, Stracieri et al. 2016). Recientemente, sin embargo, el empleo de técnicas moleculares ha permitido identificar otras especies del género asociadas a frutas de papaya: C. magna, C. brevisporum y C. truncatum (sinónimo C. capsici) (Tapia-Tussell et al. 2008, Nascimento et al. 2010, Tarnowski y Ploetz 2010, Rampersad 2011, Vieira et al. 2013, Torres-Calzada et al. 2013).
La presencia de diferentes especies de Colletotrichum en papaya tiene implicaciones en el combate de la antracnosis, ya sea mediante resistencia genética o aplicación de fungicidas. En el primer caso, la selección de variedades resistentes a una especie no necesariamente implica resistencia a otras. En el segundo, las especies varían en su sensibilidad a los fungicidas (Chen et al. 2016). En adición, estudios filogenéticos han mostrado que C. gloeosporioides y C.acutatum son en realidad complejos de especies, es decir, bajo el mismo nombre se agrupan diferentes especies. En C. gloeosporioides al menos 22 especies y una sub-especie, mientras que para C.acutatum 31 especies. Con base en estos resultados las especies se denominan C. gloeosporioides sensu stricto y C.acutatum sensu stricto mientras que los correspondientes complejos sensu lato.
En Costa Rica, C. gloeosporioides sensu lato ha sido considerada la especie causante de la antracnosis en papaya (Durán y Mora 1987, Barquero et al. 2013). En un estudio reciente, Barquero et al. (2013) analizaron 25 cepas de Colletotrichum aisladas de pecíolo (6), frutos inmaduros (6) y frutos maduros (13), recolectados en San Carlos (15), Guácimo (6) y Guápiles (4), mediante análisis moleculares con imprimadores específicos para C. gloeosporioides y C. acutatum y la prueba de sensibilidad al benomil. Todos los aislamientos fueron identificados como C. gloeosporioides. Sin embargo, 14 de estos aislamientos fueron identificados como C. acutatum mediante la prueba de sensibilidad al benomil. Según los autores, esta diferencia se debe a que estos aislamientos de C. gloeosporioides no son totalmente resistentes al benomil, pero que empiezan a mostrar resistencia parcial a este fungicida. Sin embargo, la identificación se basó en el uso de imprimadores taxón específicos, es decir, identifican C. gloeosporioides sensu lato o C. acutatum sensu lato, de manera que los 14 aislamientos podrían corresponder a una o más especies dentro del complejo C. gloeosporioides sensu lato que difieren en su sensibilidad al benomil.
El objetivo de este trabajo fue identificar las especies del género Colletotrichum asociadas a diferentes síntomas de antracnosis en frutas de papaya de la zona de Guácimo; provincia de Limón.
Materiales y Métodos
Caracterización de síntomas y obtención de aislamientos asociados
Recolección de fruta y caracterización de síntomas de antracnosis
Durante el periodo de agosto a diciembre del 2012, se recolectaron frutos de papaya híbrido Pococí de plantaciones, de aproximadamente 8 meses, ubicadas en la zona de Guácimo, provincia de Limón. Las frutas fueron llevadas al Laboratorio de Tecnología Poscosecha del Centro de Investigaciones Agronómicas de la Universidad de Costa Rica (CIA-UCR); se lavaron y se almacenaron hasta el desarrollo de lesiones (10 a 12 días después), luego se seleccionaron las frutas que presentaron diferentes síntomas de antracnosis para su caracterización con base en la forma de la lesión, el tamaño, el borde, la apariencia de la esporulación y la presencia de secreciones en las lesiones.
Obtención de aislamientos
Para la obtención de los aislamientos, el tejido sintomático, área de avance de la lesión, se desinfectó en alcohol al 95%, se realizó un corte para levantar la epidermis de la fruta y se tomó pequeñas porciones del tejido afectado de la pulpa. El tejido desinfectado se colocó en cajas Petri con medio de cultivo papa-dextrosa-agar (PDA) acidificado. Las cajas Petri se mantuvieron en una cámara de incubación a una temperatura de 22 ±2°C en oscuridad, hasta que se observó el crecimiento del hongo (3 a 5 días). Luego se transfirieron, asépticamente, discos (aproximadamente 5 mm de diámetro) del borde del crecimiento activo de la colonia a nuevas cajas Petri con medio PDA y se incubaron en las mismas condiciones antes descritas durante 7-10 días.
Obtención de aislamientos monoconidiales
Cultivos monoconidiales se obtuvieron a partir de una suspensión madre de conidios, mediante adición de aproximadamente 20 ml de agua destilada estéril con una gota de Tween 80 a la superficie de la colonia del hongo de 10 días de edad. Con ayuda de una asa se raspó la superficie para liberar los conidios. Luego se filtró la suspensión de conidios a través de una gasa y se recolectó en un beaker, que se colocó en un agitador magnético para homogenizar la suspensión de conidios. Posterioremente, se tomó un volumen de 0,3 ml y se colocó en una cámara Neubauer, y con la ayuda del microscopio se cuantificó el número de conidios en la suspensión. Finalmente, se diluyó la suspensión a una concentración de 1 x 104conidios.ml-1. De esta suspensión se colocó 0,1 ml sobre el medio de cultivo de PDA acidificado y se distribuyó homogéneamente en la caja Petri con la ayuda de una asa de Digralsky. Las cajas Petri se incubaron bajo las condiciones antes descritas por aproximadamente 24 horas. Con la ayuda de un estereoscopio se identificaron las esporas con desarrollo del tubo germinativo, se transfirieron, asépticamente y con la ayuda de un ansa-espátula, a nuevas cajas Petri con medio PDA y se incubaron a 22 ±2°C por 7 días. Los aislados se enviaron al Laboratorio de Biotecnología de Plantas del Centro de Investigaciones Agronómicas (CIA-UCR) para la identificación molecular de las especies de Colletotrichum.
Identificación molecular de las especies de Colletotrichum spp.
La extracción del ADN genómico se realizó según el método del bromuro de cetil-trimetilamonio (CTAB) descrito por Rogers y Bendich (1988), con algunas modificaciones.
La región espaciadora interna transcrita del ADN ribosomal (ITS1-5.8S e ITS-2) se amplificó mediante PCR (Reacción en Cedena de la Polimerasa) con los iniciadores universales ITS-4 (5`-TCCTCCGCTTATTGATATGC-3`) e ITS-5 (5`-GGAAGTAAAAGTCGTAACAAGG-3`) (White et al. 1990).
El producto de PCR se envió para limpieza y secuenciación en ambas direcciones, a la compañía Macrogen, Corea del Sur. Se utilizaron los mismos imprimadores que en el PCR. Las secuencias obtenidas se analizaron en el programa BioEdit (Hall 1999) y se obtuvo la secuencia consenso para cada aislamiento. Las secuencias se utilizaron para encontrar similitudes en la base de datos del Centro Nacional para la Información en Biotecnología (NCBI 2013) mediante el software de búsqueda Blastn.
La identificación de las especies de Colletotrichum asociadas a la antracnosis de papaya se corroboró mediante amplificación por PCR con el imprimador taxón específico CgInt: 5`-GGCCTCCCGCCTCCGGGCGG-3` en combinación con el imprimador ITS4 para la especie C. gloeosporioides (Salazar et al. 2012) y los imprimadores GmF: 5`-GTGAACATACCTCAAACGTTGCC-3` y GmR: 5`-GGAGGGTCCGCCACTGTATTTCG-3` para C. magna (Tsay et al. 2010). Las condiciones de amplificación fueron las descritas por los autores. La identificación de la especie C. capsici, no se corroboró por no disponer de los imprimadores específicos para esta especie.
Caracterización morfológica de los aislamientos
Simultáneamente, en el Laboratorio de Tecnología Poscosecha del Centro de Investigaciones Agronómicas (CIA-UCR), duplicados de las colonias que se enviaron a la identificación molecular, se caracterizaron morfológicamente. Las variables consideradas fueron el hábito de crecimiento del micelio (superficial o aéreo), coloración de colonia en la parte aérea y basal, cantidad, tamaño y distribución de estructuras de reproducción, presencia y ausencia de setas y forma de los conidios. Las colonias que presentaron uno o más caracteres en común, fueron agrupadas para ser comparadas con los resultados de la identificación molecular.
Prueba de patogenicidad
Se recolectaron frutas de papaya en la zona de Guácimo, con un grado 2 de maduración (<20% de amarillo), según escala de madurez establecida por Salazar (2012), las cuales fueron lavadas con agua para eliminar residuos de fungicidas y polvo. Posteriormente, la fruta fue desinfectada en agua clorada 100 mg.l-1 durante 30 segundos para eliminar cualquier posible inóculo de campo y se dejó secar. A cada papaya, se le realizaron 6 orificios con un sacabocados de aproximadamente 5 mm de diámetro, en cada uno de los cuales se colocó un disco de 5 mm de diámetro de medio con crecimiento de micelio de cada uno de los 7 aislamientos previamente identificados, el tratamiento testigo consistió de un disco que contenía únicamente PDA+AL. Las frutas inoculadas se colocaron en cámaras húmedas por 24 horas a 22±2°C y a una HR cercana al 100%. Posteriormente, se trasladaron a cámaras con una temperatura de 22±2°C, durante el resto del ensayo. Se evaluó el diámetro de cada lesión a los 4, 8 y 11 días después de inoculación. De los datos obtenidos se realizó ANDEVA y separación de medias por medio de Tukey (p≤0,05). Para comprobar los postulados de Koch, a los 11 días se hicieron reaislamientos a partir de los diferentes síntomas. De los aislamientos recuperados, se extrajo el ADN del micelio y se procedió a su identificación molecular según metodología antes descrita.
Resultados
Caracterización de síntomas y aislamientos asociados
Se identificaron 7 síntomas de antracnosis en los frutos de papaya recolectados de la zona de Guácimo, en el periodo de agosto a diciembre del 2012. Por similitudes en una o más de las características observadas como profundidad de la lesión, presencia o ausencia de secreciones y color de la esporulación, los síntomas se separaron en 3 grupos (Cuadro 1).
El grupo uno incluyó los síntomas T2 y T5, que presentaron una lesión circular, de bordes definidos, ligeramente hundida, con producción de acérvulos anaranjados y negros y esporulación abundante, brillante, y también de color naranja, destacando en el síntoma T5, una mayor abundancia de acérvulos negros.

Los siguientes 4 síntomas (TG2, T4, TG3 y A2) correspondieron al grupo 2, con lesiones circulares, de consistencia seca, en algunos casos con secreción de látex y con poca producción de acérvulos y escasa esporulación, con coalescencia de lesiones y agrietamientos de la cáscara.
Por último, en el grupo 3 se incluyó una lesión circular (CC), ligeramente hundida, con bastantes acérvulos y esporulación de color crema, con pliegues de la cáscara en los bordes de la lesión, con predominio de las lesiones individuales.
En relación con las colonias (aislados) de Colletotrichum recuperadas de los distintos síntomas, se observaron diferencias en el color de la colonia, en la parte aérea y en el reverso, en la presencia o ausencia de setas, en la cantidad de acérvulos producidos y en la forma de los conidios (Cuadro 2).
Los aislamientos T2 y T5 correspondientes a los síntomas del grupo 1, presentaron un color de colonia blanco, con crecimiento de micelio aéreo de aspecto algodonoso, con coloración crema en el reverso de la colonia y una producción escasa de acérvulos pequeños de color negro, sin setas y con una esporulación de color pardo, y conidios de forma cilíndrica ovoide (Cuadro 2). El tamaño de la colonia a los 8 días, fue intermedio en comparación con los otros grupos de aislamientos.
Los aislamientos TG2, T4, TG3, y A2 del grupo 2, presentaron una coloración de la colonia café oliváceo, con un crecimiento superficial del micelio, con micelio blanco en la periferia de algunas de las colonias y formación de estroma detectado como masas irregulares en el centro o en diferentes partes, confiriéndole una coloración oscura en el reverso de la colonia. La esporulación fue abundante, de color naranja, en acérvulos de color negro, sin setas y conidios de forma cilíndrica-ovoide (Cuadro 2). Fue el grupo que presentó el mayor crecimiento a los 8 días.
El aislamiento CC correspondiente al grupo 3, presentó una colonia con un hábito de crecimiento muy superficial y denso, de color blanco en la periferia, y color crema en el centro de la colonia, el reverso de la colonia era de color crema, con anillos concéntricos de color grisáceo, acérvulos de color negro con presencia de setas y conidios de forma falcada (Cuadro 2). Presentó el crecimiento más lento en comparación con los otros grupos de aislamientos.
Identificación molecular de las especies de Colletotrichum
La secuencia de la región ITS del ADN ribosomal de los aislamientos obtenidos de los síntomas descritos (Cuadro 1), separados por diferencias en sintomatología y características de colonia (Cuadro 2), reveló que éstos correspondieron a 3 especies del género Colletotrichum. Las especies identificadas fueron: Colletotrichum gloeosporioides, Colletotrichum magnum y Colletotrichum capsici, con una similitud entre 99 y 100% con secuencias de la misma región depositadas en el GenBank para aislamientos de estas especies (Cuadro 3).

La amplificación, mediante PCR, con los imprimadores específicos CgInt para C. gloeosporioides y GmF / GmR para C. magna, corroboraron la identidad de estas especies. Para C. capsici no se contó con imprimadores especieespecíficos, por lo que no se realizó la corroboración de su identidad. Los aislamientos T2 y T5 (Cuadro 3) mostraron la banda correspondiente de aproximadamente 400 pb con el imprimador taxón específico CgInt para C. gloeosporioides (Figura 1a); mientras que para los aislamientos T4, TG2, TG3 y A2 se obtuvo un producto de PCR de 320 pb con los imprimadores GmF y GmR correspondiente a C. magna (Figura 1b). De manera que los síntomas del grupo 1 (Cuadro 1) se asociaron a C. gloeosporioides sensu lato (Figura 1a) mientras que los síntomas del grupo 2 (Cuadro 1) a C. magnum (Figura 1b).

Fig. 1:
Electroforesis en gel de agarosa de productos de PCR a partir del ADN extraído de aislamientos de Colletotrichum spp. provenientes de frutos de papaya, híbrido Pococí, con los imprimadores CgInt para C. gloeosporioides (a), e imprimadores GmF y GmR para C. magnum (b).
Patogenicidad de aislamientos
Los frutos a los que se hicieron heridas para la inoculación de los aislados, presentaron un 100% de incidencia, y las variaciones se dieron en el tamaño de las lesiones. Se observó que todas las especies encontradas tuvieron la capacidad de infectar el tejido vegetal, por lo que se concluye que son especies patogénicas a frutos de papaya. Como se observa en la Figura 2, los aislamientos que presentaron un mayor diámetro de lesión fueron T4 y TG2, correspondientes a C. magna, seguidos por el aislamiento T5 identificado como C. gloeosporioides.

Fig. 2:
Diámetro promedio (mm) de la lesión causada por diferentes especies de Colletotrichum en frutas de papaya, híbrido Pococí.
Discusión
En el presente estudio se observaron 7 tipos de síntomas, que formaron 3 grupos según sus similitudes (Cuadro 1), asociados a la antracnosis de frutos de papaya, híbrido Pococí. La variabilidad en síntomas de antracnosis en frutos de papaya fue previamente descrita por Durán y Mora (1987) en diferentes genotipos de papaya criolla. Para estos autores, la variación en los síntomas estuvo asociada a las diferencias en genotipo del hospedante; aunque no descartaron la presencia de diferentes especies del patógeno. La identificación de 3 especies de Colletotrichum asociadas a los síntomas de antracnosis en papaya, híbrido Pococí, indica que éstos también corresponden a diferentes agentes causales y no únicamente al genotipo del hospedante. Estos resultados concuerdan con los obtenidos por Tarnowski y Ploetz (2010) en Florida (Estados Unidos) y Tapia-Tussell et al. (2008) y TorresCalzada et al. (2013) en México, quienes observaron varios tipos de síntomas de antracnosis en papaya e identificaron diferentes especies de Colletotrichum como responsables de cada síntoma. C. gloeosporioides produjo lesiones hundidas con centros de color gris oscuro y esporulación rosa/gris, que coinciden con los descritos anteriormente para la antracnosis en papaya, mientras que C. capsici produjo lesiones oscuras debido a la presencia de abundantes setas de este patógeno (Tarnowski y Ploetz 2010, Tapia-Tussell et al. 2008). Síntomas similares a los descritos para los grupos 1 y 3 (Cuadro 1) correspondientes a estas mismas especies (Cuadro 3).
Tres especies del género Colletotrichum, C. capsici, C. gloeosporioides sensu lato y C. magnum, fueron identificadas como el agente causal de la antracnosis en frutos de papaya híbrido Pococí, procedentes del cantón de Guácimo, provincia de Limón. Esto indica que varias especies son responsables de la antracnosis de papaya en Costa Rica. Hasta ahora, solo se consideraba a C. gloeosporioides como causante de la antracnosis en papaya en el país (Durán y Mora 1987, Barquero et al. 2013). Por primera vez, se identifica a C. capsici y C. magnum como causantes de la antracnosis en papaya en Costa Rica.
La identificación de las 3 especies se basó en una caracterización morfológica y molecular por lo que se considera robusta. La forma de la colonia y de los conidios observados corresponden a las descritas para C. gloesporioides (Citlali et al. 2005), C. magnum (Du et al. 2005, Nascimento et al. 2010, Tapia-Tussell et al. 2016) y C. capsici (Tapia-Tusell et al. 2008). Cabe señalar que C. gloesporioides y C. magnum son morfológicamente muy similares (Nascimento et al. 2010) Para C. capsici no se corroboró su identidad mediante imprimadores especie-específicos; sin embargo, la forma falcada (curva) de los conidios es característica de esta especie y permiten su diferenciación de las otras 2 especies, y en conjunto con la secuencia de la región ITS, provee una identificación certera de esta especie. La variación en el color de las colonias para una misma especie ha sido informada previamente en el género Colletotrichum (Torres-Calzada et al. 2013).
La presencia de múltiples especies de Colletotrichum como agentes causales de antracnosis de papaya también ha sido informada en Brasil (Nascimento et al. 2010, Vieira et al. 2013), Estados Unidos, en el estado de la Florida (Tarnowski y Ploetz 2010), México (Tapia-Tussell et al. 2008, Torres-Calzada et al. 2013) y Trinidad y Tobago (Rampersad 2011). En Florida, México y Trinidad y Tobago, C. gloeosporioides y C. truncatum (sinónimo C. capsici) infectan papaya, mientras que en Brasil se ha identificado a C. brevisporum, C. magnum y C. gloeosporioides. De manera que C. gloeosporioides y C. truncatum presentan una amplia distribución geográfica como causantes de antracnosis en papaya.
C. magna es una especie conocida como patógena de cucurbitáceas (Redman et al. 2001, Tsay et al. 2010); pero recientemente ha sido identificada en papaya en Brasil (Nascimento et al. 2010) y México (Tapia-Tussell et al. 2016) y en este estudio en Costa Rica. Esto implica un rango de hospedantes más amplio para esta especie del considerado previamente, como fue sugerido por Redman et al. (2001). Además, confirma a C. magna como agente causal de la antracnosis en papaya. Recientemente, Rossman et al. (2016) señalan que con el cambio a un nombre para especies de hongos con diferentes géneros para el estado sexual y asexual, el género Glomerella se considera ahora sinónimo de Colletotrichum, por lo que oficialmente realizaron la nueva combinación de Glomerella magnaJenkins y Winstead (1964) a Colletotrichum magnum (S.F. Jenkins & Winstead) Rossman & W.C.Allen, comb. nov. Esta nueva combinación ha sido adoptada por Tapia-Tussell et al. (2016) para C. magnum como causante de la antracnosis en papaya en México. Así la especie identificada como C magna es C. magnum.
Como se mencionó anteriormente, C. gloeosporioides ha sido considerada la especie causante de la antracnosis de papaya en Costa Rica y otros países alrededor del mundo. Sin embargo, estudios moleculares recientes indican que C. gloeosporioides es en realidad un complejo de especies, es decir un grupo de diferentes especies, al menos 22 especies y una subespecie (Weir et al. 2012, Xu et al. 2014). Actualmente se denomina al complejo de especies C. gloeosporioides sensu lato y a la especie C. gloeosporioides sensu stricto (Weir et al. 2012, Udayanga et al. 2013). En el presente trabajo se identificó a C. gloeosporioides como una de las especies causantes de antracnosis en papaya. La identificación se basó en la secuencia de la región espaciadora interna transcrita de los genes del ARN ribosomal (ITS por sus siglas en inglés) y la amplificación mediante PCR con los imprimadores CgInt e ITS4, diseñados en la misma región. En años recientes, se ha demostrado que únicamente 10 de las 22 especies del complejo C. gloeosporioides pueden ser claramente identificadas mediante la secuencia de la región ITS y que el imprimador CgInt, inicialmente diseñado como específico para C. gloeosporioides, es en realidad taxón específico, es decir identifica a C. gloeosporioides sensu lato (Afanador-Kafuri et al. 2014). De manera, que varias especies del complejo C. gloeosporioides, incluida C. gloeosporioides sensu stricto podrían causar antracnosis en frutos de papaya en Costa Rica. Para establecer si otras especies del complejo C. gloeosporioides sensu lato causan antracnosis de papaya en Costa Rica se requiere el análisis de otras regiones del genoma o análisis multilocus (Prihastuti et al. 2009) o bien un estudio polifásico (Cai et al. 2009).
La presencia de 3 especies de Colletotrichum asociadas a la antracnosis de papaya en la zona de Guácimo, plantea la interrogante sobre la distribución y abundancia de estas especies en las zonas de producción de papaya en Costa Rica: Parrita, San Carlos y Guácimo. Esta información es relevante para los programas de mejoramiento para resistencia genética a la antracnosis en papaya (Bogantes y Mora 2013). Los nuevos genotipos deben ser evaluados en zonas con una mayor diversidad genética del patógeno o bien a nivel de laboratorio con una mezcla de especies o con cada especie por separado, dado que especies de Colletotrichum difieren en su patogenicidad hacia un mismo hospedante (Sato 2016, Munir et al. 2016). En relación con el combate químico de la enfermedad, los resultados obtenidos son relevantes, ya que las especies de Colletotrichum difieren en su sensibilidad a los fungicidas (Chen et al. 2016), por tanto, la correcta identificación del patógeno a nivel de especie es fundamental para la elección de los fungicidas o sus mezclas a utilizar.
Agradecimientos
Los autores desean expresar su agradecimiento a FITTACORI por su apoyo en el financiamiento parcial de esta investigación.
Literatura Citada
Afanador-Kafuri, L; González, A; Gañán, L; Mejía, JF; Cardona, N; Alvarez, E. 2014. Characterization of the Colletotrichum species causing anthracnose in Andean blackberry in Colombia. Plant Disease 98:1503-1513.
Bailey, J; Jeger, M. 1992. Colletotrichum: Biology, Pathology and Control. C.A.B. International: Wallingford UK.
Barquero, M; Perez, A; Arauz LF. 2013. Presencia de Colletotrichum acutatum y Colletotrichum gloeosporioides en helecho hoja de cuero, limón criollo, papaya, crambola y mango en Costa Rica y Florida (Estados Unidos). Agronomía Costarricense 37(1):23-38.
Bogantes, A; Mora, E. 2013. Incidencia y severidad de la antracnosis en líneas e híbridos de papaya (Carica papaya). Agronomía Mesoamericana 24(2):411-417.
Cai, L; Hyde, K; Taylor, P; Weir, B; Waller, J; Abang, M; Zhang, J; Yang, Y; Phoulivong, S; Liu, Z; Prihastuti, H; Shivas, R; Mckenzie, E; Johnston, P. 2009. A poliphasic approach for studying Colletotrichum. Fungal Diversity 39:183-204.
Chen, SN; Luo, CX; Hu, MJ; Schnabel, G. 2016. Sensitivity of Colletotrichum species, including C. fioriniae and C. nymphaeae, from peach to demethylation inhibitor fungicides. Plant Disease 100(12):2434-2441.
Citlali, R; Bravo, L; Corona, M; Orona, M; Villa, P; Bautista, S; Barrera, L. 2005. Caracterización morfocultural y sintomatológica de dos aislamientos de Colletotrichum gloeosporioides (Penz.) Penz. y Sacc. de papayo (Carica papaya L.). Revista Mexicana de Fitopatología 23 (3):223-231.
Durán, A; Mora, D. 1987. Variabilidad en la sintomatología de la antracnosis (Colletotrichum sp.) en papaya postcosecha en Costa Rica. Agronomía Costarricense 11(2):155-161.
Du, M; Shrdl, CL; Nuckles, EM; Vaillancourt, LJ. 2005. Using mating-type gene sequence for improve phylogenetic resolution of Colletotrichum species complexes. Mycologia 97:641-658.
Hall, TA. 1999. BioEdit: a user-friendly biological sequence alignment editor and analysis program for Windows 95/98/NT. Nucleic Acids Symposium Series 41:95-98.
Jenkins, SF; Winstead, NN. 1964. Glomerella magna, cause of a new anthracnose of cucurbits. Phytopathology 54:452-454.
Munir, M; Amsden, B; Dixon, E; Vaillancort, L; Gauthier, NAW. 2016. Characterization of Colletotrichum species causing bitter rot of apples in Kentucky orchards. Plant Disease 100:2194-2203.
Nascimento, RJ; Mizubuti, ESG; Câmara, MPS; Ferreira, MF; Maymon, M; Freeman, S; Michereff, SJ. 2010. First report of papaya fruit rot caused by Colletotrichum magna in Brazil. Plant Disease 94(12):1506.
NCBI (The National Center for Biotechnology Information). 2013. Gen bank (en línea). U.S.A. Consultado 19 julio 2013. Disponible en Disponible en http://www.ncbi.nlm.nih.gov
Prihastuti, H; Cai, L; Chen, H; McKenzie, E; Hyde, K. 2009. Caractherization of Colletotrichum species associated with coffee berries in northern Thailand. Fungal Diversity 39:89-109.
Rampersad, SN. 2011. Molecular and phenotypic characterization of Colletotrichum species associated with anthracnose disease of papaya in Trinidad. Plant Disease 95(10):1244-1254.
Redman, R; Dunigan, D; Rodríguez, R. 2001. Fungal simbiosis from mutualism to parasitism: who controls the outcome, host or invader? New Phytologist 151:705716.
Rogers, S; Bendich, A. 1988. Extraction of DNA from plant tissues. In: Gelvin, SB; Schilperoort, R.A. (eds.) Plant Molecular Biology Manual. Dordrecht, Netherlands: Kluwer Academic Publishers. pp. A6/1-11.
Rossman, AY; Allen, WC; Castlebury, LA. 2016. New combinations of plant -associated fungi resulting from the change to one name for fungi. IMA FUNGUS 7(1):1-7.
Salazar, D. 2012. Establecimiento de la escala de madurez y potencial de vida útil durante el almacenamiento de papaya (Carica papaya L.). Tesis Lic. San José, Costa Rica, Universidad de Costa Rica. 91 p.
Salazar, E; Hernández, R; Tapia, A; Gómez, L. 2012. Identificación molecular del hongo Colletotrichum spp., aislado de banano (Musa spp.) de altura en la zona de Turrialba y determinación de su sensibilidad a fungicidas poscosecha. Agronomía Costarricense 36(1):53-68.
Sato, T. 2016. Studies on the taxonomy and identification of plant pathogenic fungi, based on morphology and phylogenetic analyses, and fungal pathogenicity focused on host specificity. J Gen Plant Pathol 82:332-337.
Simmonds, J. 1965. Papaw diseases. Queensland Agricultural Journal 91(11):666-677.
Straicieri, J; Dias-Pereira, F; Da Silveira, AL; Magalhães, HM; De Goes, A. 2016. Morphocultural and molecular characterization of papaya tree Colletotrichum spp. African Journal of Agricultural Research 11(9):17551764.
Tapia-Tussell, R; Cortes-Velazquez, A; Valencia-Yah, T; Navarro, C; Espinoza, E; Moreno, B; Perez-Brito, D. 2016. First report of Colletotrichum magnum causing anthracnose in papaya in Mexico. Plant Disease 100(11):2323.
Tapia-Tussell, R; Quijano, A; Cortes, A; Lappe, P; Larque, A; Perez-Brito, D. 2008. PCR-based detection and characterization of the fungal pathogens Colletotrichum gloeosporioides and Colletotrichum capsici causing antracnose in papaya (Carica papaya L.) in the Yucatan Peninsula. Mol Biotechnol 40:293-298.
Tarnowski, T; Ploetz, R. 2010. First report of Colletotrichum capsici causing postharvest anthracnose on papaya in South Florida. Plant Disease 94(8):1065.
Torres-Calzada, C; Tapia, R; Higuera, I; Perez, D. 2013. Morphological, pathological and genetic diversity of Colletotrichum species responsable for antracnose in papaya (Carica papaya L). Europe Journal Pathology 135:67-79.
Tsay, J; Chen, R; Wang, W; Weng, B. 2010. First report of anthracnose on curcubitaceous crops caused by Glomerella magna in Taiwan. Plant Disease 94(6):787.
Udayanga, D; Manamgoda, DS; Liu, X; Chukeatirote, E; Hyde, KD. 2013. What are the common anthracnose pathogens of tropical fruits?. Fungal Diversity 61:165-179.
Vieira, WAS; Nascimento, RJ; Michereff, SJ; Hyde, KD; Câmara, PS. 2013. First report of papaya fruit anthracnose caused by Colletotrichum brevisporum in Brazil. Plant Disease 97(12):1659.
Weir, B; Johnston, P; Damm, U. 2012. The Colletotrichum gloeosporioides species complex. Studies in Micology 73:115-180.
White, TJ; Bruns, T; Lee, S; Taylor, J. 1990. Amplification and direct sequencing of fungal ribosomal RNA genes for phylogenetics. In: Innis, MA; Gelfand, DH; Sninsky, JJ; White, TJ. (eds.). PCR protocols: a guide to methods and applications, New York, Academic Press Inc. pp. 315-322.
Xu, X; Lin, T; Yuan, S; Dai, D; Shi, H. 2014. Characterization of baseline sensitivity and resistance risk of Colletotrichum gloeosporioides complex isolates from strawberry and grape two demethylationinhibitor fungicides, procloraz and tebuconazole. Australassian Plant Pathology Society 43(6):605-613.
Notas
Notas de autor
*Autora para correspondencia. Correo electrónico: gerardina.umana@ucr.ac.cr